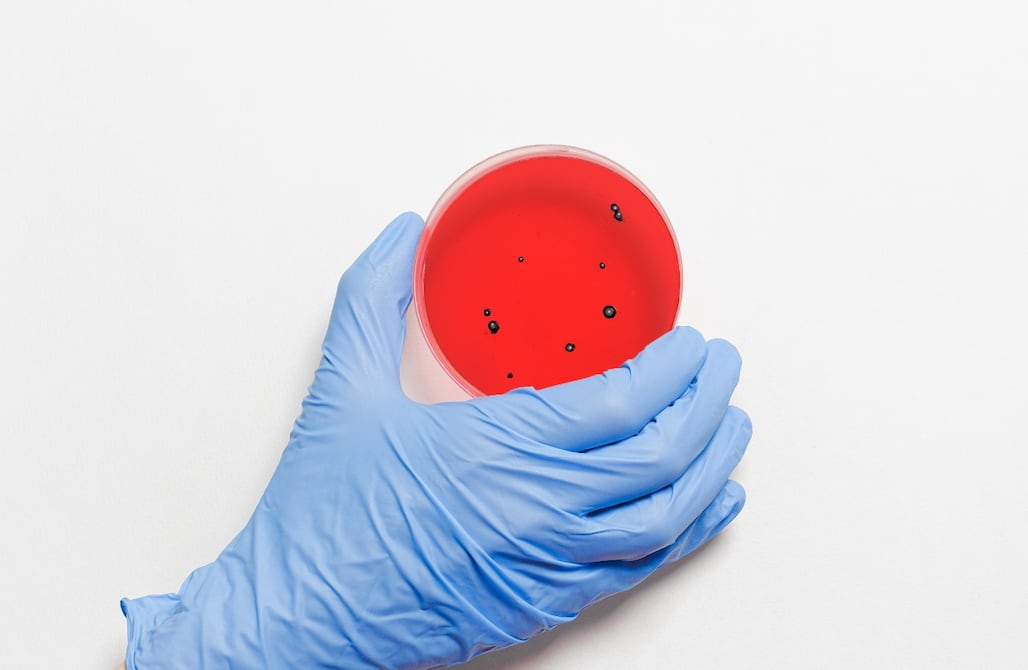

Coloquialmente conocidos como “hongos negros”, unos microorganismos que producen una infección potencialmente mortal y poco común ha hecho saltar las alarmas en Chile, donde recientemente se reportó el primer caso de este patógeno en un paciente con covid-19.